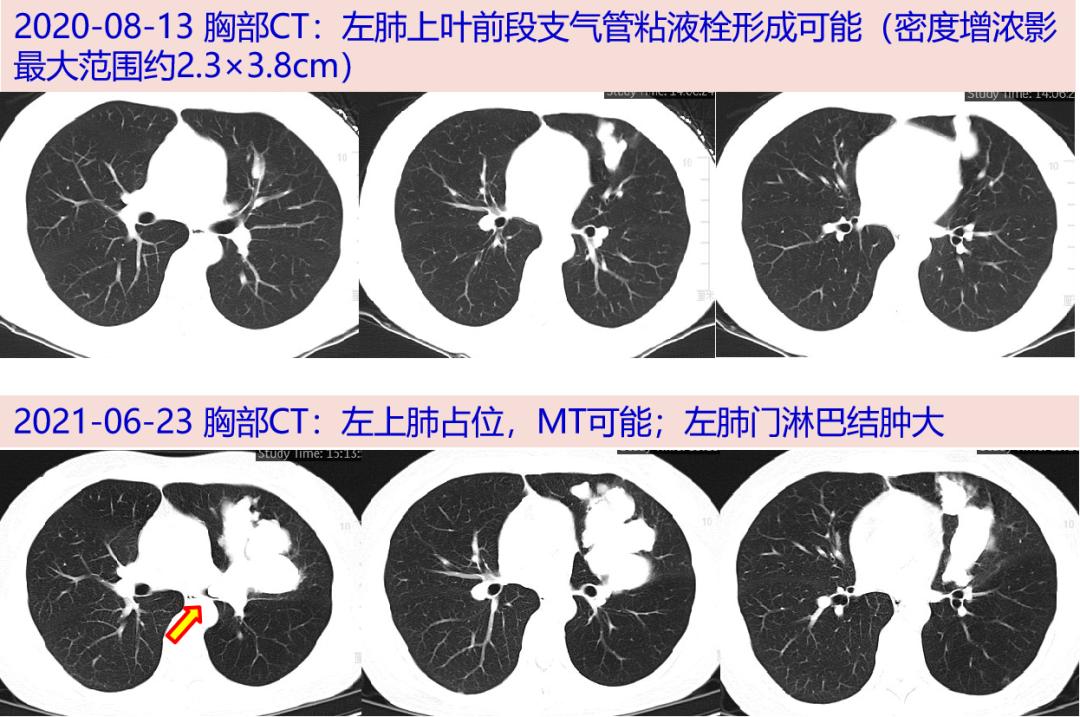
探案丨发现痰栓一年仅留一线的呼吸

气管内痰栓ct图片影像

ct发现右下叶支气管痰栓形成
图片尺寸1810x1404
俊豪老师肺部粘液栓病变
图片尺寸2200x764
cl2763:支气管痰栓
图片尺寸715x993
支气管黏液栓塞的影像诊断与鉴别
图片尺寸819x432
疑难用经方梁爱武支扩并痰栓案两则
图片尺寸903x697
疑难用经方梁爱武支扩并痰栓案两则
图片尺寸905x699
支气管黏液栓塞的影像诊断与鉴别
图片尺寸640x328
俊豪老师肺部粘液栓病变
图片尺寸1440x1080
这种ct,能想到支气管扩张合并痰栓,说明阅片医生还是很有水平呢.
图片尺寸630x522
疑难用经方梁爱武支扩并痰栓案两则
图片尺寸921x696
疑难用经方梁爱武支扩并痰栓案两则
图片尺寸579x420
疑难用经方梁爱武支扩并痰栓案两则
图片尺寸887x695
探案丨发现痰栓一年仅留一线的呼吸
图片尺寸1080x717
探案丨发现"痰栓"一年,仅留"一线" 的呼吸
图片尺寸1080x321
【内二科】支气管镜下取出巨大痰栓 还患者自由呼吸
图片尺寸1080x810
写美篇 支气管内有痰栓
图片尺寸1600x1200
疑难用经方梁爱武支扩并痰栓案两则
图片尺寸579x415
疑难用经方梁爱武支扩并痰栓案两则
图片尺寸579x400
"致命霉栓"(1)---阻塞性支气管毛霉病 - 好大夫在线
图片尺寸524x670
急性肺栓塞的肺ct血管造影
图片尺寸800x650